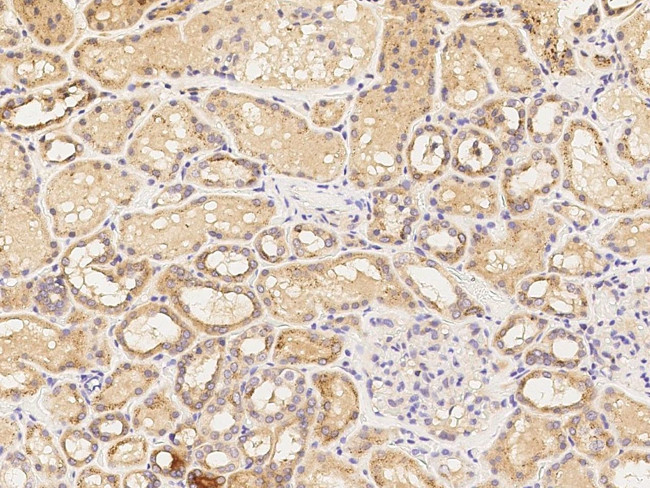
DPP2 Antibody in Immunohistochemistry (Paraffin) (IHC (P))

Search
Invitrogen
DPP2 Polyclonal Antibody
{{$productOrderCtrl.translations['antibody.pdp.commerceCard.promotion.promotions']}}
{{$productOrderCtrl.translations['antibody.pdp.commerceCard.promotion.viewpromo']}}
{{$productOrderCtrl.translations['antibody.pdp.commerceCard.promotion.promocode']}}: {{promo.promoCode}} {{promo.promoTitle}} {{promo.promoDescription}}. {{$productOrderCtrl.translations['antibody.pdp.commerceCard.promotion.learnmore']}}
产品信息
PA5-80560
种属反应
宿主/亚型
分类
类型
抗原
偶联物
形式
浓度
规格
纯化类型
保存液
内含物
保存条件
运输条件
RRID
产品详细信息
This product is preservative free. It is recommended to add sodium azide to avoid contamination (final concentration 0.05%-0.1%).
This antibody has specificity for Human DPP7/DPPII/DPP2.
靶标信息
The protein encoded by this gene is a post-proline cleaving aminopeptidase expressed in quiescent lymphocytes. The resting lymphocytes are maintained through suppression of apoptosis, a state which is disrupted by inhibition of this novel serine protease. The enzyme has strong sequence homology with prolylcarboxypeptidase and is active at both acidic and neutral pH.
仅用于科研。不用于诊断过程。未经明确授权不得转售。
篇参考文献 (0)
生物信息学
蛋白别名: carboxytripeptidase; Dipeptidyl aminopeptidase II; dipeptidyl arylamidase II; Dipeptidyl peptidase 2; Dipeptidyl peptidase 7; Dipeptidyl peptidase II; dipeptidyl-peptidase II; DPP II; Quiescent cell proline dipeptidase; unnamed protein product
基因别名: DPP; DPP II; DPP2; DPP7; DPPII; II; QPP
UniProt ID: (Human) Q9UHL4
Entrez Gene ID: (Human) 29952